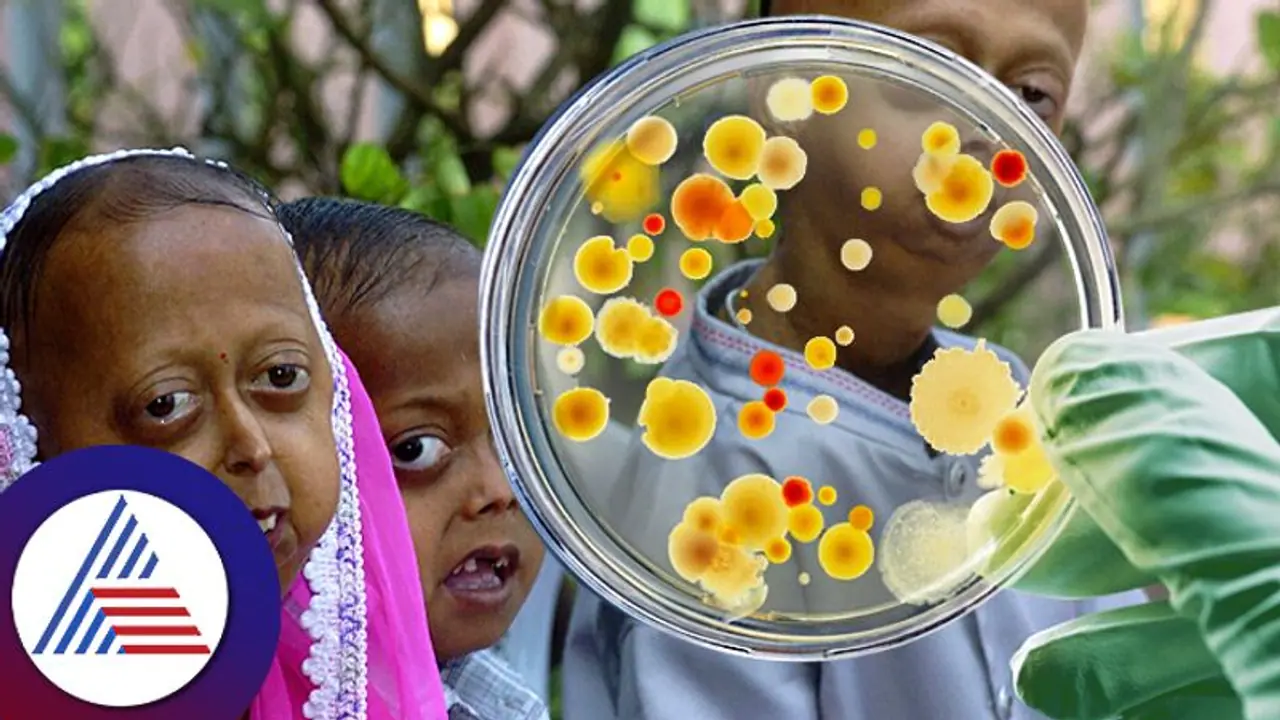
ಜಗತ್ತಿನಲ್ಲಿ ಎಂಥೆಂಥ ಚಿತ್ರ ವಿಚಿತ್ರ ಕಾಯಿಲೆಗಳು ಇವೆ ಗೊತ್ತಾ?

ವೈದ್ಯಕೀಯ ಕ್ಷೇತ್ರದಲ್ಲಿ ಸಾಕಷ್ಟು ಬೆಳವಣಿಗೆ ಆದಂತೆ ಹೊಸ ಹೊಸ ಖಾಯಿಲೆಗಳನ್ನು ಪತ್ತೆ ಮಾಡಲಾಗ್ತಿದೆ. ಆದ್ರೆ ಪತ್ತೆಯಾದ ಎಲ್ಲ ಖಾಯಿಲೆಗೆ ಔಷಧಿ ಇಲ್ಲ. ಕೆಲವೊಂದು ಹೀಗೂ ಇರುತ್ತಾ ಎಂಬ ಪ್ರಶ್ನೆಯುಂಟು ಮಾಡುವ ರೋಗ ನಮ್ಮಲ್ಲಿದೆ.
ಜಗತ್ತಿನಲ್ಲಿ ದಿನೇ ದಿನೇ ಹೊಸ ಹೊಸ ಖಾಯಿಲೆಗಳು ಉದ್ಭವವಾಗುತ್ತಿವೆ. ಹಿಂದೆಂದೂ ಕಂಡು ಕೇಳರಿಯದ ವಿಚಿತ್ರ ಖಾಯಿಲೆಗಳ ಬಗ್ಗೆ ಪ್ರತಿನಿತ್ಯವೂ ನಾವು ಕೇಳುತ್ತಿರುತ್ತೇವೆ. ಕೆಲವು ಗುಣಪಡಿಸಲಾಗದ ಮಾರಣಾಂತಿಕ ರೋಗವಾದರೆ ಕೆಲವು ರೋಗಗಳಿಗೆ ಸುಲಭವಾದ ಚಿಕಿತ್ಸೆಗಳು ಲಭ್ಯವಿದೆ. ಬದಲಾಗಿರುವ ಆಹಾರ ಪದ್ಧತಿ, ಜೀವನಶೈಲಿಯಿಂದಲೋ ಅಥವಾ ಕಲುಷಿತ ವಾತಾವರಣದಿಂದಲೋ ಮನುಷ್ಯ ಅನೇಕ ರೀತಿಯ ರೋಗಗಳಿಗೆ ತುತ್ತಾಗುತ್ತಿದ್ದಾನೆ.
ಇಂದಿನ ಕೆಲವು ರೋಗ (Disease) ಗಳು ವೈದ್ಯಲೋಕಕ್ಕೆ ಸವಾಲಾಗಿ ನಿಂತಿವೆ. ರೋಗವನ್ನು ಪತ್ತೆ ಹಚ್ಚಲು ಹಾಗೂ ಅದಕ್ಕೆ ಸೂಕ್ತ ಚಿಕಿತ್ಸೆ (Treatment) ಯನ್ನು ಕಂಡುಹಿಡಿಯಲು ವೈದ್ಯ (Doctor) ರು ಹರಸಾಹಸ ಪಡುತ್ತಿದ್ದಾರೆ. ವೈದ್ಯಕೀಯ ಜಗತ್ತು ಎಷ್ಟೇ ಮುಂದುವರೆದಿದ್ದರೂ ಕೆಲವು ವಿಚಿತ್ರ ರೋಗಗಳಿಗೆ ಚಿಕಿತ್ಸೆಯನ್ನು ಕಂಡುಹಿಡಿಯಲಾಗದೇ ಕೈ ಚೆಲ್ಲಿ ಕೂತಿದೆ. ಅಂತಹ ಕೆಲವು ಭಯಾನಕ ಹಾಗೂ ವಿಚಿತ್ರ ಖಾಯಿಲೆಗಳ ಬಗ್ಗೆ ಒಂದಿಷ್ಟು ಮಾಹಿತಿ ಇಲ್ಲಿದೆ.
ಮುಖ, ತುಟಿ ಊದಿಕೊಂಡಿದ್ದ ವ್ಯಕ್ತಿಯ ಟೆಸ್ಟ್ ಮಾಡಿದ ವೈದ್ಯರಿಗೇ ಶಾಕ್, ಮೂಗಿನೊಳಗೆ ಅಂಟಿಕೊಂಡಿತ್ತು 150 ಹುಳು!
ಜಗತ್ತಿನಲ್ಲಿರುವ ವಿಚಿತ್ರ ಕಾಯಿಲೆ :
ಅಕ್ವಾಜೆನಿಕ್ ಉರ್ಟ್ರೇರಿಯಾ : ನಮ್ಮ ದೇಹವು ಪ್ರತಿಶತ 60 ರಷ್ಟು ನೀರಿನಿಂದಲೇ ಮಾಡಲ್ಪಟ್ಟಿದೆ. ನೀರು ಮನುಷ್ಯನ ಅನೇಕ ಅಗತ್ಯತೆಗಳನ್ನು ಪೂರೈಸುತ್ತದೆ. ಆದರೆ ಕೆಲವು ಮಂದಿಗೆ ನೀರೇ ಅಲರ್ಜಿ. ಇಂತಹ ನೀರಿನ ಅಲರ್ಜಿಯನ್ನು ಅಕ್ವಾಜೆನಿಕ್ ಉರ್ಟ್ರೇರಿಯಾ ಎಂದು ಕರೆಯುತ್ತಾರೆ. ಈ ಖಾಯಿಲೆಯನ್ನು ಹೊಂದಿರುವ ವ್ಯಕ್ತಿ ನೀರಿನ ಸಂಪರ್ಕಕ್ಕೆ ಹೋದರೆ ಆತನ ದೇಹದ ಮೇಲೆ ದದ್ದುಗಳು ಉಂಟಾಗುತ್ತವೆ. ಈ ರೋಗಕ್ಕೆ ಒಳಗಾದವರು ಸ್ನಾನ ಮಾಡಲು ಕೂಡ ಸಾಧ್ಯವಿಲ್ಲ.
ಹಚಿನನ್ಸ್ – ಗಿಲ್ಫೋರ್ಡ್ ಪ್ರೊಜೆರಾಯ್ಡ್ ಸಿಂಡ್ರೋಮ್ (HGPS) : ಹಚಿನನ್ಸ್ – ಗಿಲ್ಫೋರ್ಡ್ ಪ್ರೊಜೆರಾಯ್ಡ್ ಸಿಂಡ್ರೋಮ್ ಗೆ ಒಳಗಾದವರ ಮೂಳೆಗಳು ಬೇಗ ದುರ್ಬಲವಾಗುತ್ತದೆ. ಮೂತ್ರಪಿಂಡಗಳು ವಿಫಲವಾಗಬಹುದು ಮತ್ತು ಕಣ್ಣುಗಳು ದುರ್ಬಲಗೊಳ್ಳುತ್ತವೆ. ಇದಕ್ಕೆ ಯಾವುದೇ ಚಿಕಿತ್ಸೆಯಿಲ್ಲ. ಈ ರೋಗಕ್ಕೆ ಒಳಗಾದ ಮಕ್ಕಳು ಬಹಳ ಬೇಗ ವಯಸ್ಸಾದವರಂತೆ ಕಾಣಿಸುತ್ತಾರೆ. ಅಮಿತಾಬ್ ಬಚ್ಚನ್ ಅಭಿನಯದ ‘ಪಾ’ ಚಿತ್ರವನ್ನು ನೋಡಿದವರಿಗೆ ಈ ಖಾಯಿಲೆಯ ಬಗ್ಗೆ ಹೆಚ್ಚಿನ ಅರಿವು ಇರುತ್ತೆ.
ಫೀಶ್ ಓಡರ್ ಸಿಂಡ್ರೋಮ್ : ನಾವು ಮಾರುಕಟ್ಟೆಗಳಿಗೆ ಹೋದಾಗ ಅಲ್ಲಿ ಮೀನಿನ ವಾಸನೆ ಬಂದರೆ ಮೂಗು ಹಿಡಿದುಕೊಳ್ಳುತ್ತೇವೆ. ಟ್ರೈಮಿಥೈಲಾಮಿನೂರಿಯಾ ಫಿಶ್ ಓಡರ್ ಸಿಂಡ್ರೋಮ್ ಹೊಂದಿರುವ ವ್ಯಕ್ತಿಯ ಬಳಿ ಹೋದರೂ ಇದೇ ರೀತಿಯ ಕೊಳೆತ ಮೀನಿನ ವಾಸನೆ ಬರುತ್ತದೆ. ಈ ಖಾಯಿಲೆಗೆ ಕೂಡ ಇದುವರೆಗೆ ಯಾವುದೇ ಚಿಕಿತ್ಸೆಯನ್ನು ಕಂಡುಹಿಡಿಯಲು ಆಗಲಿಲ್ಲ. ಆಹಾರ, ಸಾಬೂನು, ಲೋಷನ್ ಮುಂತಾದವುಗಳ ಮೂಲಕ ಇದರ ಪರಿಣಾಮವನ್ನು ಸ್ವಲ್ಪ ಮಟ್ಟಿಗೆ ಕಡಿಮೆ ಮಾಡಬಹುದು.
ಬೆಳಗ್ಗೆ ಅಥವಾ ಮಧ್ಯಾಹ್ನ, ಯಾವ ಸಮಯದಲ್ಲಿ ಎಳನೀರು ಕುಡಿಯೋದು ಆರೋಗ್ಯಕ್ಕೆ ಬೆಸ್ಟ್?
ಆಲಿಸ್ ಇನ್ ವಂಡರ್ಲ್ಯಾಂಡ್ ಸಿಂಡ್ರೋಮ್ : ಆಲಿಸ್ ಇನ್ ವಂಡರ್ಲ್ಯಾಂಡ್ ಖಾಯಿಲೆಯು ಅಪರೂಪದ ನರವೈಜ್ಞಾನಿಕ ಸ್ಥಿತಿಯಾಗಿದೆ. ಇದು ವ್ಯಕ್ತಿಯ ಪಂಚೇಂದ್ರಿಯಗಳಿಗೂ ಪರಿಣಾಮ ಬೀರುತ್ತದೆ. ಇಂಗ್ಲೀಷ್ ಲೇಖಕ ಲೂಯಿಸ್ ಕ್ಯಾರೊಲ್ ಅವರು ಆಲಿಸ್ ಇನ್ ವಂಡರ್ಲ್ಯಾಂಡ್ ಸಿಂಡ್ರೋಮ್ ಕುರಿತು ಬರೆದ ಕಥಾಸರಣಿ ಅತ್ಯಂತ ಜನಪ್ರೀಯತೆ ಪಡೆದಿದೆ. ಈ ಖಾಯಿಲೆಗೆ ಒಳಗಾದ ವ್ಯಕ್ತಿಯ ಆಲೋಚನಾ ಶಕ್ತಿ ಕಡಿಮೆಯಾಗುತ್ತದೆ ಮತ್ತು ಆತ ಭ್ರಮೆಯಲ್ಲಿರುತ್ತಾನೆ. ಈ ರೋಗಕ್ಕೆ ಯಾವುದೇ ರೀತಿಯ ಚಿಕಿತ್ಸೆಯಿಲ್ಲ.
ಫಾರೆನ್ ಎಕ್ಸೆಂಟ್ ಸಿಂಡ್ರೋಮ್ : ಒಬ್ಬ ವ್ಯಕ್ತಿಗೆ ಆತ ವಾಸಿಸುವ ಸ್ಥಳದಲ್ಲಿನ ಭಾಷೆ ರೂಢಿಯಲ್ಲಿರುತ್ತದೆ. ಕೆಲವು ಇತರ ಭಾಷೆಗಳನ್ನು ಆತ ಕಲಿಯಬಲ್ಲನಾದರೂ ಹೊರ ದೇಶಗಳ ಭಾಷೆ, ಉಚ್ಛಾರಣೆ ಹಾಗೂ ಮಾತನಾಡುವ ಶೈಲಿಯನ್ನು ಆತ ಅಳವಡಿಸಿಕೊಳ್ಳಲು ಸಾಧ್ಯವಿಲ್ಲ. ಆದರೆ ಫಾರೆನ್ ಎಕ್ಸೆಂಟ್ ಸಿಂಡ್ರೋಮ್ ಖಾಯಿಲೆ ಇರುವವರು ಯಾವುದೇ ತರಬೇತಿಯಿಲ್ಲದೇ ವಿದೇಶೀ ಉಚ್ಛಾರಣೆಯನ್ನು ಮಾಡುತ್ತಾರೆ. ಮೆದುಳಿನ ಭಾಗ ಘಾಸಿಯಾದಾಗ ನರವೈಜ್ಞಾನಿಕ ಖಾಯಿಲೆಯಾದ ವಿದೇಶೀ ಉಚ್ಛಾರಣಾ ಸಿಂಡ್ರೋಮ್ ಸಂಭವಿಸುತ್ತದೆ.